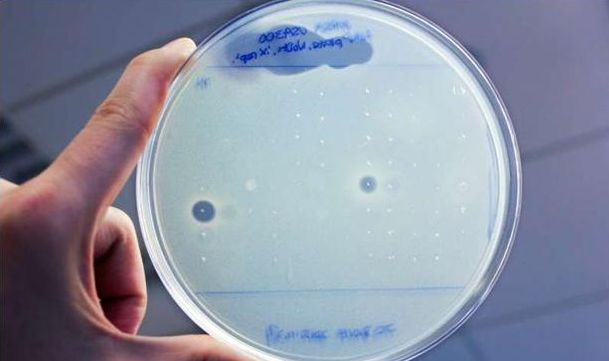

目前使用的大多数抗生素其实是细菌产生的天然分子。由于细菌耐药性的不断增强,医学方面迫切需要研发新的抗生素。然而,诱导细菌产生新的抗生素是一件棘手的事。大多数细菌不会在实验室中生长,就算实验室中培养出了这些细菌,大多数的产生抗生素的基因很少表达。近日,洛克菲勒大学(Rockefeller University)的研究人员找到了解决问题的新方法。
研究人员发现杀死抗药性金黄色葡萄球菌的新抗生素Humimycin A和Humimycin B
研究人员从公共基因数据库中找到存在人体内的细菌基因组,然后使用专门的计算机软件扫描数百个特定编译合成非核糖体肽分子的基因簇,这些非核糖体肽是形成许多抗生素的基础。最后他们使用软件来预测基因簇产生的分子化学结构。通过使用计算方法来选出微生物基因组中产生抗生素化合物的基因,然后跳过细菌培养过程直接合成这些化合物本身,用此类方法,他们已经成功找到两种新型抗生素。
发掘huminmycin之旅
从软件最初确定的57个潜在有用的基因簇中,研究人员进一步筛选出了30个基因簇。布兰迪和他的同事们然后使用一种固相肽合成的方法制造出了25种不同的化合物。
通过测试这些化合物对人类病原体的反应,研究人员成功筛选出了两种抗生素,他们将其命名为Humimycin A和Humimycin B。两者都发现于一种称为红球菌属细菌中,这是传统细菌培养中从未发现的新抗生素。
葡萄球菌和链球菌是两大危害人体的细菌,近年来它们对各种抗生素逐渐表现出抗性。实验表明,humimycins通过抑制细菌细胞壁合成酶 来切断细胞壁合成途径,细菌当即死亡。因而humimycins对这两类细菌十分有效。
Humimycins的作用还不止如此。β-内酰胺是一类广泛应用的处方抗生素,其效果常常随着细菌出现抗药性而消失。然而科学家们发现,其中一种humimycins可以用来重新敏化细菌,消除细菌对β-内酰胺的抗药性。
神奇的协同作用
在实验中,他们将具有β-内酰胺抗性的葡萄球菌暴露于与β-内酰胺抗生素和humimycin A的混合物中,发现细菌立刻死亡。即使Humimycin A含量很少时,相同结果仍然出现。因此布兰迪猜测两种抗生素都对中断细菌生命活动起到了作用。
为了进一步验证推论,布兰迪和他的同事们用具有β-内酰胺抗性的金黄色葡萄球菌感染小鼠。他们发现用含有humimycin A和β-内酰胺抗生素的混合物处理的小鼠的效果远远优于仅用任何其中一种药物的小鼠。这给人们治疗抗药性金黄色葡萄球菌提供了一条新思路。
布兰迪希望这一发现能够激发更多科研团队挖掘细菌基因组,找到更多的新型抗生素。除此之外,布兰迪建议大家的眼光可以不用局限在人体微生物的基因组,微生物的基因组是一片巨大的宝藏,等待着人类去开采。



